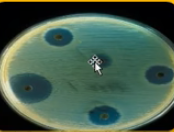
Alexander Fleming

-
 estudio de tejidos, rede de capilares y glóbulos rojos
estudio de tejidos, rede de capilares y glóbulos rojos -
 observa en materia vegetal , células muertas. Da nombre por su parecido a CELDA.
observa en materia vegetal , células muertas. Da nombre por su parecido a CELDA. -
 Observa a través del microscopio simples pequeños organismos, describe espermatozoides y glóbulos rojos
Observa a través del microscopio simples pequeños organismos, describe espermatozoides y glóbulos rojos -
 La biología como ciencia
La biología como ciencia -
 "la vida surge a partir de la vida"
"la vida surge a partir de la vida"
Fase del desarrollo del huevo de la rana -
 Los seres vivos forman vesículas o células (protoplasma)
Los seres vivos forman vesículas o células (protoplasma)
Aporte a la teoría celular -
 Denomina al protoplasma al liquido que llena la célula
Denomina al protoplasma al liquido que llena la célula -
 Los organismos vegetales están compuestos de células
Los organismos vegetales están compuestos de células -
 todas las cosas vivientes están compuestas de células
todas las cosas vivientes están compuestas de células -
 Las células se originan de células ya existentes
Las células se originan de células ya existentes -
 Las células vienes por otras células por división de otras células
Las células vienes por otras células por división de otras células -
 Evolución de las especies por selección natural
Evolución de las especies por selección natural -
 Observo el núcleo de las células
Observo el núcleo de las células -
 Generación espontanea
Generación espontanea -
 Papel de la herencia y los mecanismos de la genética
Papel de la herencia y los mecanismos de la genética -
 Aísla moléculas acidas ricas en fosfato en núcleos de glóbulos blancos. Actualmente llamada en acido nucleico.
Aísla moléculas acidas ricas en fosfato en núcleos de glóbulos blancos. Actualmente llamada en acido nucleico. -
 Cambios que se producen durante la división celular "MITOSIS"
Cambios que se producen durante la división celular "MITOSIS" -
 Descubre el fenómeno de la fagocitosis, un gran avance en la inmunología
Descubre el fenómeno de la fagocitosis, un gran avance en la inmunología -
 Demuestra la individualidad de las neuronas
Demuestra la individualidad de las neuronas -
 tinción de tejidos y células
tinción de tejidos y células -
Desarrolla investigaciones en inmunología
Desarrolla investigaciones en inmunología
Descubre LIsozimas, penicilina -
 Invento el primer microscopio electrónico en 1928
Invento el primer microscopio electrónico en 1928
Premio nobel de física en 1986 -
 Estudia con el Difractómetro de rayos X la columna vertebral del ADN
Estudia con el Difractómetro de rayos X la columna vertebral del ADN -
 Modelo estructura doble hélice del ADN
Modelo estructura doble hélice del ADN
Premio nobel del química 1962 -
 Teoría de la Endosimbiosis para explicar el origen de las células eucariotas
Teoría de la Endosimbiosis para explicar el origen de las células eucariotas -
 Rector de la universidad de california crea un instituto para secuenciar el ADN
Rector de la universidad de california crea un instituto para secuenciar el ADN
El departamento de energía de los estados unidos (DOE)
Lo integra al proyecto efecto de los programas nucleares en la genética -
 Clonación de un mamífero a partir de las células de un ejemplar adulto. La oveja DOLLY
Clonación de un mamífero a partir de las células de un ejemplar adulto. La oveja DOLLY
Looking for a timeline maker?
Create timelines for projects, roadmaps, history, lessons, legal cases, and stories with Timetoast. Timetoast is a timeline maker for work, school, research, and stories.
